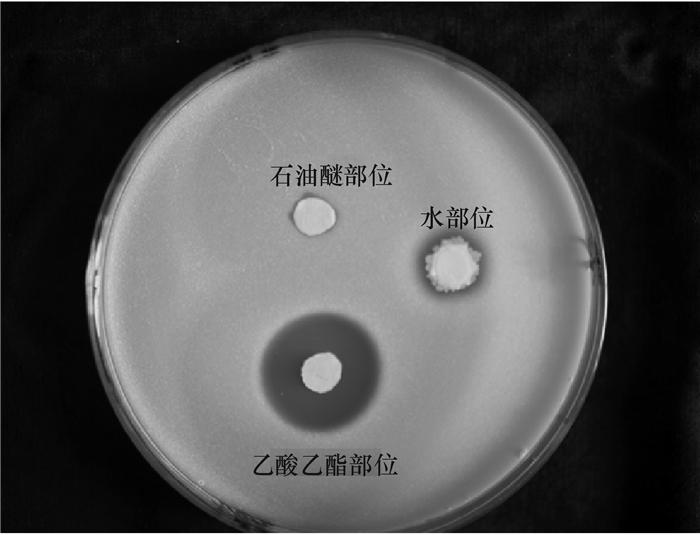

2. 中国科学院 华南植物园/植物资源保护与利用重点实验室,广州 广东 510650
2. South China Botanical Garden, Chinese Academy of Sciences/Key Laboratory of Plant Resources Conservation and Sustainable Utilization, Guangzhou 510650, China
解淀粉芽孢杆菌Bacillus amyloliquefaciens是目前生防细菌中研究较多的一类,因其能够产生具有耐热、耐旱、抗紫外线和有机溶剂功能的内生孢子, 是筛选生防菌比较理想的对象[1-2]。解淀粉芽孢杆菌抑菌范围很广,主要包括根部病害、叶部病害和收获后果品病害,如大豆根腐病、番茄青枯病、苹果红腐病、小麦赤霉病及其他一些土传和地上部病害等[3-4]。在这些抗菌化合物中,环状脂肽如表面活性素(Surfactins)、伊枯草菌素(Iturins)和丰原素(Fengycins或Plipastatins)具有非常显著的抑制各种微生物的活性。它们的靶标都是在细胞质膜上[5]。本文研究的解淀粉芽孢杆菌HN011菌株是一种生防菌,对多种病原真菌均有明显的拮抗作用。平板对峙试验和生长速率试验表明,HN011菌株对香蕉枯萎病病原菌、番茄颈腐根腐病病原菌、菜心炭疽病病原菌、水稻稻瘟病菌、水稻纹枯病菌有明显的抑菌效果;滤纸片法试验表明,HN011发酵液对水稻白叶枯病菌、金黄色葡萄球菌也有明显的抑菌现象[6]。对其次级代谢产物鲜见报道。本文对其次级代谢产物进行深入研究,旨在为下一步提高其生物防治效果提供理论依据。
1 材料与方法 1.1 材料 1.1.1 供试菌株生防菌:解淀粉芽孢杆菌HN011;病原菌:金黄色葡萄球菌Staphylococcus aureus。均由华南农业大学天然农药与化学生物学教育部重点实验室提供。
1.1.2 供试试剂石油醚、乙酸乙酯、氯仿、正丁醇、甲醇等,均为广州化学试剂厂生产的分析纯;氘代二甲基亚砜和氘代甲醇,均为美国剑桥公司(CIL)产品;YPD培养基:酵母粉5 g,牛肉膏3 g,蛋白胨20 g,葡萄糖12.5 g,蒸馏水1 L;柱层析硅胶为青岛海洋化工厂产品(100~200目,200~300目);反相硅胶层析为德国Merck公司产品。
1.1.3 供试仪器HEV- 50型灭菌器,Hirayama公司;1702-MP8型电子天平,德国Startorius公司生产;SHIMADU LC-6AD/RID-10A(示差检测器)(日本Shimadzu公司生产);色谱柱为XTerra Prep MS C18 Column (19 mm×300 mm×10 μm和4.6 mm×250 mm×10 μm);旋转蒸发仪型号为EYELA N-1001;EYELA,A-1000S型循环水真空泵;EYELA CA-1111型低温冷却液循环泵,Tokyo Rikakai Co. Ltd.生产;电热恒温水浴锅为上海精宏实验设备有限公司生产;MDS SCIEX API 2000LC/MS/MS质谱仪,美国Applied Biosystems公司生产;BRUKER AV 600 M核磁共振波谱仪,瑞士布鲁克公司生产。
1.2 方法 1.2.1 活性部位初探将供试生防菌株HN011在YPD培养基上活化后,挑取1环接种于含25 mL YPD培养液的250 mL三角瓶中,28 ℃、170 r·min-1振荡培养2 d,取5 mL种子液接种于1 L的YPD培养液中,28 ℃、170 r·min-1振荡培养2 d,得到发酵液。冷冻离心去除菌体后,利用石油醚、氯仿、乙酸乙酯、正丁醇对发酵液进行分步液-液萃取3次,旋转蒸发得浸膏。利用牛津杯法对各个萃取部位浸膏进行金黄色葡萄球菌抑制活性试验,确定活性部位。在相同条件下进行放大发酵(53 L)培养,发酵培养后,除去菌体,分步萃取,得乙酸乙酯浸膏30.6 g,备用。
1.2.2 活性部位大柱分段将活性部位浸膏,利用正相硅胶色谱分离方法,氯仿-甲醇系统进行梯度洗脱,根据主点,分成若干个馏分段,对各馏分段进行取样, 利用牛津杯法进行金黄色葡萄球菌抑制活性试验,确定各馏分段的活性。
1.2.3 各馏分的细分将活性馏分段通过ODS反相中压色谱分离方法进行细分,结合凝胶柱色谱和高效液相色谱分离方法,分离出活性馏分段的单体化合物。同时,为了更好地阐述生防菌HN011的次级代谢产物,活性较弱的馏分段利用各种分离技术,分离单体化合物。
1.2.4 单体化合物的结构鉴定各个馏分段分离出的单体化合物通过核磁共振波谱仪和质谱仪等波谱方法进行结构鉴定。
2 结果 2.1 活性部位初探的结果1 L的生防菌HN011发酵液通过冷冻离心去除菌体,分别用等比例不同极性的有机溶剂萃取3次,通过旋转蒸发回收有机溶剂得石油醚部位浸膏0.41 g、氯仿部位浸膏0.22 g、乙酸乙酯部位浸膏0.42 g、正丁醇部位浸膏1.10 g。各部位的金黄色葡萄球菌抑制试验结果表明,乙酸乙酯部位的抑菌圈最大,其次是氯仿部位、石油醚部位、正丁醇部位,水部位基本没有活性(图 1)。考虑到乙酸乙酯部位和氯仿部位都具有活性,并且氯仿和乙酸乙酯的化学极性相差不大,放大发酵后,去除菌体的发酵液经过石油醚萃取后,直接使用乙酸乙酯进行萃取,余下水部位,3个组分的金黄色葡萄球菌抑制试验结果(图 2)表明,石油醚部位和水部位抑菌圈较小,而乙酸乙酯部位抑菌圈较大,和预期的结果一致,生防菌HN011的活性次级代谢产物都可以被乙酸乙酯萃取出来。

|
图 1 少量发酵液萃取物对金黄色葡萄球菌抑制活性试验结果 Figure 1 The inhibitory activities of zymotic fluid extracts against Staphylococcus aureus by a small amount of fermentation |
|
图 2 放大发酵萃取物对金黄色葡萄球菌抑制活性试验结果 Figure 2 The inhibitory activities of zymotic fluid extracts against Staphylococcus aureus after amplifying fermentation |
利用正相硅胶色谱分离技术将30.6 g乙酸乙酯部位浸膏进行分段。30 g正相硅胶拌样后,采用φ为100%氯仿湿法装柱干法上样的方法,氯仿-甲醇系统进行梯度洗脱,根据柱体积2 000 mL,以500 mL为1个小馏分,每个梯度洗脱3~4个柱体积。TLC色谱方法分析各个小馏分后,根据主点合并得10个馏分段。利用牛津杯法,对各馏分进行金黄色葡萄球菌抑制活性试验,结果(图 3)表明,馏分E7的活性最明显,馏分E6次之,E3和E8较弱,其他的馏分活性不明显。

|
图 3 乙酸乙酯部位各馏分段金黄色葡萄球菌抑制活性 Figure 3 The inhibitory activity of each fraction of ethyl acetate portion against Staphylococcus aureus |
将活性馏分段E7(4.0 g)通过ODS反相中压色谱分离技术进行分离,得到12个小组分,其中小组分4、6、7、8有明显的主点。通过HPLC结合凝胶柱色谱分离技术对4个小组分进行分离,得到单体化合物E7-4、E7-6、E7-7、E7-8。通过核磁共振氢谱和核磁共振碳谱进行结构解析,并用质谱进行验证,参考和比对文献,鉴定化合物E7-4为Cyclic(Thr-Leu),E7-6为Cyclic(Tyr-Val),E7-7为Cyclic(Tyr-Trp)(图 4a)。

|
图 4 活性馏分段分离出的化合物 Figure 4 The compounds isolated from the activity fractions |
将活性馏分段E6(2.6 g)通过ODS反相中压色谱进行分离,得到14个小组分,其中小组分4、5、13有明显的主点,通过HPLC分析,发现E6的13个小组分和E7-8出峰时间一致,利用薄层色谱技术进行比对,Rf一致,证明E6-13就是Cyclic(Phe-Tyr)。小组分4、5通过制备液相得到化合物E6-4和E6-5,利用核磁共振氢谱和核磁共振碳谱进行结构解析,并用质谱进行验证,参考和比对文献,鉴定化合物E6-4为Cyclic(Phe-Gly),E6-5为Cyclic(Phe-Ala)(图 4b)。
通过ODS反相中压色谱进行分离得若干个小组分,根据TLC判断主点明显的小组分进行分离,结合凝胶色谱分离技术、高效液相色谱和制备液相色谱分离技术,分离得到单体。通过核磁共振氢谱和核磁共振碳谱,并用质谱进行验证,参考和比对相关文献,鉴定相关的化合物。从馏分段E3(2.2 g)分离出化合物E3-23;馏分段E8(1.4 g)分离出化合物E8-6B(图 4c); 馏分段E4(7.4 g)分离出化合物E4-2A、E4-3A、E4-10A、E4-10B(图 5a);馏分段E5(6.1 g)分离出化合物E5-4A、E5-4B、E5-4C(图 5b)。

|
图 5 活性不明显馏分段分离出的化合物 Figure 5 The compounds isolated from the inconspicuous activity fractions |
化合物E7-4:白色粉末(甲醇),1H NMR (600 MHz, DMSO) δ 8.18 (d, J=2.5 Hz, 1H), 7.99 (d, J=2.7 Hz, 1H), 5.00 (d, J=5.5 Hz, 1H), 4.04~3.92 (m, 1H), 3.67~3.61 (m, 1H), 3.49 (t, J=2.6 Hz, 1H), 1.80 (dq, J=13.1, 6.6 Hz, 1H), 1.69 (ddd, J=14.1, 9.3, 5.0 Hz, 1H), 1.58 (ddd, J=13.6, 9.3, 4.6 Hz, 1H), 1.08 (d, J=6.6 Hz, 1H), 0.86 (d, J=6.6 Hz, 3H), 0.83 (d, J=6.5 Hz, 3H);13C NMR (150 MHz, DMSO) δ 169.14, 167.24, 67.13, 60.97, 53.20, 45.47, 23.78, 23.63, 21.97, 20.60。从核磁共振碳谱低场δ 169.14,167.24说明是2个酰胺上的碳,结合核磁共振氢谱δ 8.18, 7.99这2个氮上的活泼氢,说明是一个典型环二肽结构。有2个二重峰的甲基,有1个低场的二重峰的甲基,同时δ 5.00是一个二重峰,说明含有1个羟基。同时质谱结果显示,相对分子质量为214.04,结合文献[7],推导E7-4结构为Cyclic(Thr-Leu)。
化合物E7-7:白色粉末(甲醇),1H NMR (600 MHz, DMSO) δ 9.19 (s, 1H), 7.82 (d, J=2.5 Hz, 1H), 7.63 (d, J=2.5 Hz, 1H), 7.48 (d, J=8.0 Hz, 1H), 7.32 (d, J=8.1 Hz, 1H), 7.10~7.02 (m, 1H), 7.02~6.94 (m, 2H), 6.58 (d, J=8.5Hz, 2H), 6.51 (d, J=8.5 Hz, 2H), 3.94 (t, J=6.3 Hz, 1H), 3.77 (d, J=6.9 Hz, 1H), 2.79 (dd, J=14.5, 4.3 Hz, 1H), 2.43 (ddd, J=18.1, 14.0, 5.5 Hz, 2H), 1.78 (dd, J=13.6, 7.0 Hz, 1H);13C NMR (150 MHz, DMSO) δ 167.25, 166.76, 156.43, 136.53, 131.15, 127.93, 126.86, 124.84, 121.35, 119.19, 118.89, 115.36, 111.78, 109.34, 56.33, 55.70, 31.14, 30.39。如图 6所示,根据核磁共振碳谱δ 167.25, 166.76和核磁共振氢谱δ 7.82, 7.63这2个二重峰的活泼氢,表明化合物含有一个典型的环二肽骨架。从核磁共振氢谱δ 6.58 (d, J=8.5 Hz, 2H), 6.51 (d, J=8.5 Hz, 2H),结合碳谱δ156.43的碳,说明含有1个对位羟基取代的苯环;低场芳香区有个邻位取代苯环,同时质谱结果显示,相对分子质量为349.14。结合文献[8],推导E7-7结构为Cyclic(Tyr-Trp)。

|
图 6 E7-7核磁共振氢谱和碳谱图 Figure 6 The spectra of proton NMR and carbon NMR of E7-7 |
化合物E7-6:13C NMR(150 MHz, DMSO) δ 167.94, 166.75, 156.85, 131.70, 126.33, 115.33, 56.15, 52.73, 44.18, 38.18, 23.41, 23.25, 21.81。结合质谱和文献[9],推导E7-6的结构为Cyclic(Tyr-Val)。
化合物E7-8:13C NMR (150 MHz, DMSO) δ 166.73, 166.63, 156.56, 137.12, 131.28, 130.20, 128.64, 126.90, 115.48, 56.18, 55.86, 38.99。结合质谱和文献[10],推导E7-8结构为Cyclic(Phe-Tyr)。
化合物E6-5:13C NMR (150 MHz, DMSO) δ 168.12, 166.27, 136.50, 130.82, 128.47, 127.10, 55.81, 50.17, 20.14。结合质谱和文献[10],推导化合物E6-5结构为Cyclic(Phe-Ala)。
化合物E6-4:13C NMR (150 MHz, DMSO) δ 167.59, 166.09, 136.43, 130.50, 128.57, 127.20, 55.94, 44.13。结合质谱和文献[11],推导化合物E6-4结构为Cyclic(Phe-Gly)。
化合物E3-23:13C NMR (150 MHz, DMSO) δ 170.50, 165.67, 59.64, 58.64, 45.08, 35.34, 28.37, 24.32, 22.47, 15.41, 12.71。结合质谱和文献[10],推导化合物E3-23结构为Cyclic (Ile-Pro)。
化合物E8-6B:13C NMR (150 MHz, CD3OD) δ 169.27, 167.32, 156.54, 131.33, 125.65, 114.88, 56.17, 50.32, 38.12, 19.01。结合质谱和文献[12],推导化合物E8-6B结构为Cyclic(Tyr-Leu)。
化合物E4-2A:13C NMR (150 MHz, DMSO) δ 170.70, 165.67, 59.93, 58.69, 45.08, 28.30, 28.15, 22.53, 18.78, 16.84。结合质谱和文献[13],推导化合物E4-2A结构为Cyclic(Pro-Val)。
化合物E4-3A:13C NMR (150 MHz, DMSO) δ 169.35, 169.31, 53.89, 49.42, 42.58, 24.08, 23.34, 22.24, 18.29。结合质谱和文献[12],推导化合物E4-3A结构为Cyclic(Ala-Leu)。
化合物E4-10B:13C NMR (150 MHz, DMSO) δ 168.89, 167.29, 59.98, 52.85, 44.39, 40.53, 40.41, 40.27, 40.13, 40.00, 39.86, 39.72, 39.58, 31.91, 24.01, 23.54, 22.22, 19.21, 17.80。结合质谱和文献[14],推导化合物E4-10B结构为Cyclic(Leu-Val)。
化合物E5-4A:1H NMR (600 MHz, CD3OD) δ 7.05 (d, J=8.5 Hz, 2H), 6.72 (d, J=8.6 Hz, 2H), 4.37 (td, J=5.1, 1.9 Hz, 1H), 4.05 (ddd, J=10.9, 6.3, 1.9 Hz, 1H), 3.56 (dt, J=11.9, 8.4 Hz, 1H), 3.40 ~ 3.33 (m, 1H), 3.07 (ddd, J=31.4, 14.2, 4.9 Hz, 1H), 2.11 (dtd, J=10.7, 6.0, 4.4 Hz, 1H), 1.87 ~ 1.76 (m, 1H), 1.30 ~1.19 (m, 1H)。结合质谱和文献[14],化合物E5-4A为Cyclic(Tyr-Pro)。
化合物E5-4B:13C NMR (150 MHz, CD3OD) δ 169.84, 167.80, 59.50, 50.24, 38.86, 24.23, 19.50, 14.13, 10.77。结合质谱和文献[11],化合物E5-4B为Cyclic(Ala-Ile)。
化合物E5-4C: 13C NMR (150 MHz, CD3OD) δ 170.05, 169.54, 53.22, 50.52, 43.64, 23.89, 22.11, 20.69, 19.45。其中E5-4C的核磁共振氢谱δ 0.99 (d, J=6.6 Hz, 3H), 0.97 (d, J=6.6 Hz, 3H),而E5-4B的核磁共振氢谱δ 1.04 (d, J=7.1 Hz, 3H), 0.97 (t, J=7.4 Hz, 3H), 说明E5-4B含有异亮氨酸而E5-4C含有亮氨酸。结合质谱和文献[14],化合物E5-4C为Cyclic(Ala-Leu)。
3 结论生防菌HN011对多种病原菌均有明显的拮抗作用,通过滤纸片试验表明HN011发酵液对金黄色葡萄球菌、水稻白叶枯病菌有明显的抑菌现象。但目前鲜见对其有效成分进行报道。因此,有必要对生防菌HN011的次级代谢产物进行研究。本研究通过少量发酵,对发酵液不同的极性段进行分部,通过活性跟踪,确定了活性部位主要集中在乙酸乙酯部位和氯仿部位,由于氯仿部位的活性和极性与乙酸乙酯部位差别不明显,因此放大发酵后,为了节省时间和成本,在使用石油醚进行萃取后,直接使用乙酸乙酯对水相进行萃取,旋转蒸发后得浸膏。对乙酸乙酯部位的浸膏30.6 g进行划段和活性试验,结果表明活性物质主要集中在馏分6和馏分7中,对这2个活性段进行分离,得到6个单体化合物。其中化合物E7-7[Cyclic(Tyr-Trp)]首次在细菌中被发现。为了系统了解生防菌代谢产物的类型,对其他的活性不明显的馏分段进行分离, 得到9个单体化合物。单体化合物通过核磁共振氢谱、核磁共振碳谱和质谱进行结构鉴定,结果表明通过活性追踪等方法,生防菌HN011发酵液活性段的次级代谢产物主要是一些环二肽。
环二肽是由2个氨基酸通过肽键环合形成的二酮哌嗪类化合物,也是自然界中最小的环肽化合物, 具有多种生物活性[15]。近年来,环二肽在生物防治的运用上也屡有发现。在试验分离中,次级产物全部是环二肽,说明环二肽在防治上有重大的意义。环二肽及其衍生物具有多种生物活性,尤其是在抑菌方面具有显著的效果。艾峰等[16]从东海微生物中分离出6种对鳗弧菌具有显著抑制活性的环二肽;诺尔斯链霉菌Streptomyces noursei Hazen的次生代谢产物白诺氏菌素(Albonoursin)为Cyclo(Phe-Leu)的四脱氢衍生物, 具有显著抗菌作用[17]。生防菌活性代谢产物的分离是在抑制金黄色葡萄球菌的指示下进行的,试验结果表明各组分的抑菌活性不一致,分离的结果显示各组分的成分也不同,说明生防菌HN011不同的代谢产物具有不同的生物活性;生防菌具有显著的抑制各种病原菌的作用很大程度是因为其代谢产物具有多样性。
| [1] |
JOSEPH O, LISE K. Integrated control of citrus green and blue molds using Bacillus subtilis in combination with sodium bicarbonate or hot water[J]. Postharvest Bio Tec, 2003, 28(1): 187-194. DOI:10.1016/S0925-5214(02)00145-X (  0) 0) |
| [2] |
FRAVEL D R. Commercialization and implementation of biocontrol[J]. Annu Rev Phytopathol, 2005, 43: 337-359. DOI:10.1146/annurev.phyto.43.032904.092924 (  0) 0) |
| [3] |
STEIN T. Bacillus subtilis antibiotics: Structures, syntheses and specific functions[J]. Mol Microbiol, 2005, 56(4): 845-857. DOI:10.1111/j.1365-2958.2005.04587.x (  0) 0) |
| [4] |
ONGENA M, JACQUES P. Bacillus lipopeptides: Versatile weapons for plant disease biocontrol[J]. Trends Microbiol, 2008, 16(3): 115-125. DOI:10.1016/j.tim.2007.12.009 (  0) 0) |
| [5] |
KEIJITSU T, ATSUSHI I, HIROMITSU N. Isolation of anteiso-C17, iso-C17, iso-C16, and iso-C15 bacillomycin D from Bacillus amyloliquefaciens SD-32 and their antifungal activities against plant pathogens[J]. J Agr Food Chem, 2014, 62(7): 1469-1476. DOI:10.1021/jf404531t (  0) 0) |
| [6] |
康向辉. 枯草芽孢杆菌HN09的抑菌活性及其生物药肥的研制[D]. 广州: 华南农业大学, 2014.
(  0) 0) |
| [7] |
郭琼, 彭光天. 南海珊瑚Montipora sp.内生细菌Brevibacterium sp.中的环二肽成分研究:Ⅱ[J]. 中国海洋药物, 2014, 33(3): 13-19. (  0) 0) |
| [8] |
SHAABAN M, MAGDY E M, NASRH. A new diketopiperazine alkaloid from Aspergillus oryzae[J]. Nat Prod Res, 2014, 28(2): 86-94. DOI:10.1080/14786419.2013.841687 (  0) 0) |
| [9] |
TIAN S Z, PU X. Isolation and characterization of new p-terphenyls with antifungal, antibacterial, and antioxidant activities from Halophilic actinomycete Nocardiopsis gilva YIM 90087[J]. J Agr Food Chem, 2013, 61(12): 3006-3012. DOI:10.1021/jf400718w (  0) 0) |
| [10] |
付银丹, 李振麟, 濮社班, 等. 多棘蜈蚣化学成分的研究: Ⅰ[J]. 中草药, 2013, 44(13): 1726-1729. (  0) 0) |
| [11] |
李德海, 朱天骄, 朱伟明, 等. 海洋放线菌11014中抗肿瘤活性成分的研究: Ⅰ:环二肽[J]. 中国抗生素杂志, 2005, 30(8): 449-454. DOI:10.3969/j.issn.1001-8689.2005.08.001 (  0) 0) |
| [12] |
朱建生, 包卫洋. 海洋细菌Pseudomonas putida中具有抗硅藻附着的活性成分[J]. 微生物学报, 2013, 53(8): 825-831. (  0) 0) |
| [13] |
王彧博, 田黎, 陈刚, 等. 真菌Nigrospora sp.Z18-17的化学成分[J]. 沈阳药科大学学报, 2013, 30(2): 91-95. (  0) 0) |
| [14] |
沈明曦, 裴月湖, 田黎, 等. 海洋细菌成团泛菌Pantoea agglonerans中环二肽类代谢产物的研究[J]. 沈阳药科大学学报, 2011, 28(5): 350-353. (  0) 0) |
| [15] |
杨子娟, 向兰, 邢杰, 等. 环二肽的研究进展[J]. 现代药物与临床, 2009, 24(2): 73-82. (  0) 0) |
| [16] |
艾峰, 许强芝, 杨妤, 等. 东海微生物中6种环二肽类天然活性物质的分离和鉴定[J]. 第二军医大学学报, 2006, 27(1): 22-24. DOI:10.3321/j.issn:0258-879X.2006.01.006 (  0) 0) |
| [17] |
LAUTRU S, GONDRY M, GENET R, et al. The albonoursin gene cluster of S. noursei: Biosynthesis of diketopiperazine metabolites independent of nonribosomal peptide synthetases[J]. Chem Biol, 2002, 9(12): 1355-1364. DOI:10.1016/S1074-5521(02)00285-5 (  0) 0) |
 2016, Vol. 37
2016, Vol. 37


